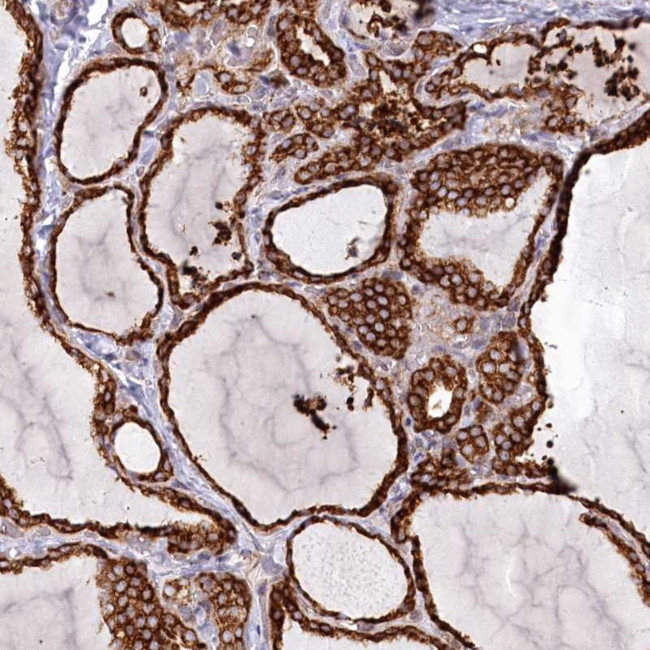
POGLUT1 Antibody in Immunohistochemistry (Paraffin) (IHC (P))

Search
Invitrogen
POGLUT1 Polyclonal Antibody
{{$productOrderCtrl.translations['antibody.pdp.commerceCard.promotion.promotions']}}
{{$productOrderCtrl.translations['antibody.pdp.commerceCard.promotion.viewpromo']}}
{{$productOrderCtrl.translations['antibody.pdp.commerceCard.promotion.promocode']}}: {{promo.promoCode}} {{promo.promoTitle}} {{promo.promoDescription}}. {{$productOrderCtrl.translations['antibody.pdp.commerceCard.promotion.learnmore']}}
产品信息
PA5-83393
种属反应
宿主/亚型
分类
类型
抗原
偶联物
形式
浓度
规格
纯化类型
保存液
内含物
保存条件
运输条件
RRID
产品详细信息
Immunogen sequence: KESGSKWKVF IDQINRSLEN YEPCSSQNCS CYHGVIEEDL TPFRGGISRK MMAEVVRRKL GTHYQITKNR LYRENDCMFP SRCSGVEHFI L
Highest antigen sequence indentity to the following orthologs: Mouse - 93%, Rat - 92%.
靶标信息
KTELC1 also termed as CLP46 is a glucosyltransferase, which implicates in Protein modification and glycosylation. KTELC1 encodes a 392 amino acids protein and its molecular weight is 46 kDa, but is exists glycosylation modification. KTELC1 is localized in endoplasmic reticulum lumen and abundantly expressed in liver, brain, heart, skeletal muscle, spleen, kidney, placenta, lung and peripheral blood leukocyte. KTELC1 may regulation in cell proliferation and Notch signal pathway.
仅用于科研。不用于诊断过程。未经明确授权不得转售。
篇参考文献 (0)
生物信息学
蛋白别名: 9630046K23Rik; CAP10-like 46 kDa protein; CAP10-like protein; hCLP46; hRumi; KDELC family like 1; KTEL (Lys-Tyr-Glu-Leu) containing 1; KTEL motif-containing protein 1; MDS010; Myelodysplastic syndromes relative protein; O-glucosyltransferase Rumi homolog; Protein O-glucosyltransferase 1; Protein O-xylosyltransferase POGLUT1; unnamed protein product; x 010 protein
基因别名: C3orf9; CLP46; hCLP46; KDELCL1; KTELC1; LGMD2Z; LGMDR21; MDS010; MDSRP; POGLUT1; Rumi; UNQ490/PRO1006
UniProt ID: (Human) Q8NBL1
Entrez Gene ID: (Human) 56983